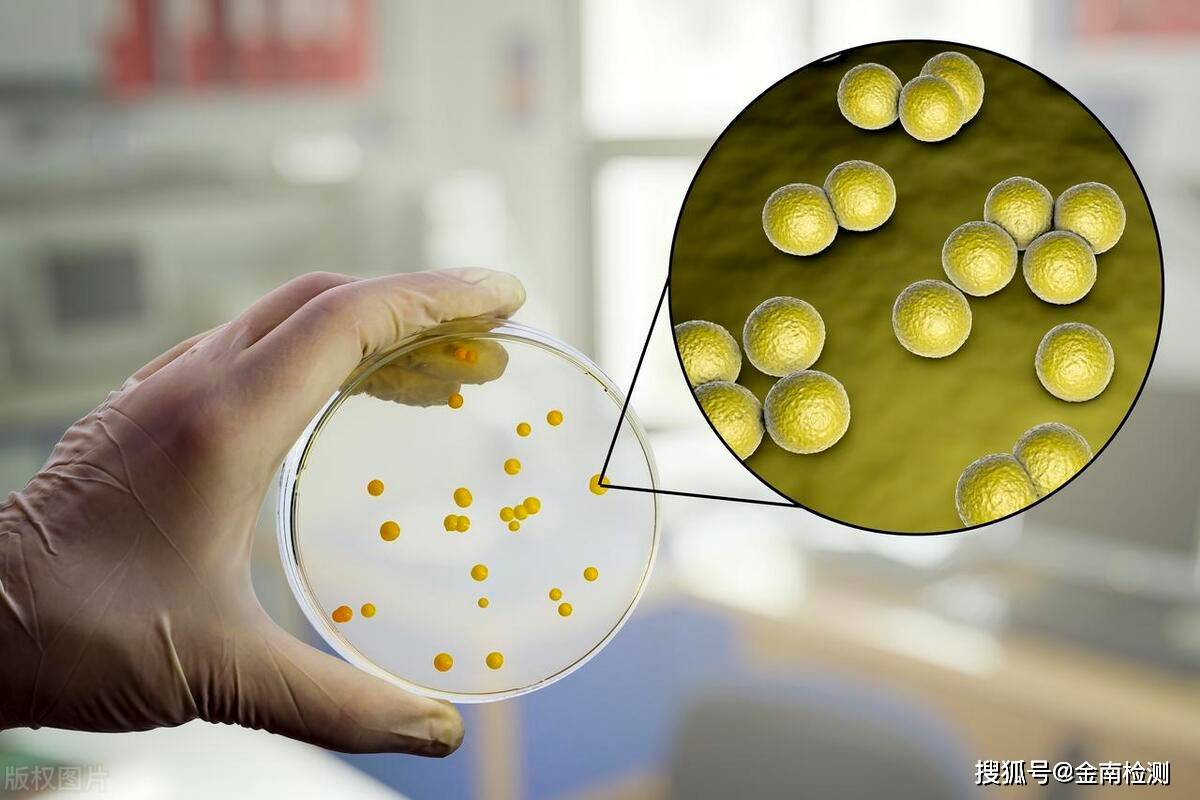

更新时间:2026-02-02
更新时间:2026-02-02 点击次数:
点击次数:
YYVIP易游·(中国有限公司)官方网站-微生物生长意味着原生质含量的增加,所以测定的方法也都直接或间接的以次为根据,而测定繁殖则都要建立在计数这一基础上。微生物生长的衡量,可以从其重量,体积,密度,浓度,做指标来进行衡量。

培养法:利用不同的培养基和条件,将微生物从样品中分离出来,并观察其形态、数量和特性。这种方法可以直接鉴定微生物的种类和数量,但需要较长的时间和专业的实验设备。

显微法:利用显微镜或电子显微镜等仪器,直接观察样品中的微生物。这种方法可以快速地发现微生物的存在和形态,但不能确定其种类和数量。

微生物测试片检测技术:待测样品经过处理后可直接接种在微生物测试片上,然后放置在适宜的温度下培养——使固定在测试片上的显色物质与待检微生物生长产生的特异性酶发生显色反应,形成有颜色的菌落,通过对这些菌落进行计数便可实现检测。
分子法:利用核酸杂交、聚合酶链反应(PCR)、基因芯片等技术,检测样品中的特定微生物的核酸序列。这种方法可以高度敏感和特异地识别微生物的种类,但需要较高的技术水平和成本。
免疫法:利用抗原-抗体反应,检测样品中的特定微生物或其产物。这种方法可以快速地筛选出感染或污染的样品,但不能提供详细的信息。
细菌结构分析:通过拉曼光谱的特征结构峰体现活性物质和含量的差异,根据这些差异可以快速无损的进行细菌种类的鉴别和分析。
单个细菌检测:通常细菌的体积较小,信号较弱,溶液中细菌浓度较低时,很难检测到有效的化学结构信息,尤其是需要对单个细菌的化学结构进行检测和分析。在进行分子结构分析时,需要高灵敏度和高空间分辨率的拉曼技术。